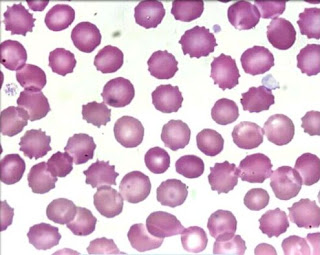

Los hematíes son las células de la sangre encargadas del transporte del oxígeno al organismo y del dióxido de carbono para su eliminación. Contienen en su interior una proteína compleja, en cuya molécula está presente el hierro, que confiere a la sangre su color rojo característico y denominada hemoglobina (Hb), esencial para dicha función de transporte.
También llamados eritrocitos o glóbulos rojos, los hematíes pueden presentar variaciones en su tamaño, forma y color.
ALTERACIONES DE TAMAÑO:
Los hematíes normocíticos presentan las siguientes dimensiones:
- Diámetro longitudinal: 7-8 µm
- Diámetro transversal (espesor):
- periférico: 2µm
- central: 1µm
- Superficie: 120-140 µm2
- Volumen: 80-100 µm
Anisocitosis
Consiste en la coexistencia, en una misma muestra de sangre, de hematíes de distintos tamaños. Se produce, por ejemplo, en los pacientes transfundidos
Microcitosis
Consiste en la existencia de unos hematíes con un diámetro longitudinal inferior a 7 µm y un volumen inferior a 80 µm3. Se produce en la talasemia, en la anemia sideroacréstica y, sobretodo, en la anemia ferropénica.
Macrocitosis
Consiste en la existencia de unos hematíes con un diámetro longitudinal superior a 8 µm y un volumen superior a 100 µm3. Se produce en el alcoholismo y en las hepatopatías crónicas.
Megalocitosis
Consiste en la existencia de unos hematíes con un diámetro longitudinal superior a 11 µm. Se produce en la anemia megaloblástica.
ALTERACIONES DE FORMA:
Los hematíes normocíticos poseen una forma de disco bicóncavo sin núcleo.
Acantocitosis
Consiste en la existencia de unos hematíes con espículas de longitud y posición irregular (acantocitos). Se produce en la abetalipoproteinemia y en la cirrosis hepática
Dianocitosis
Consiste en la existencia de unos hematíes planos y con una forma de sombrero mexicano. Esto hace que los hematíes, vistos frontalmente, tengan un reborde colorado, que delimita una zona anular pálida, cuyo centro también está coloreado. Ello les confiere una imagen en diana y por eso, reciben el nombre de dianocitos. Se produce en latalasemia y en las hepatopatías.
Drepanocitosis
Consiste en la existencia de unos hematíes con una forma de hoz. Se produce en la anemia de células falciformes.
Eliptocitosis
Consiste en la existencia de unos hematíes con una forma elíptica y oval. Se produce en la anemia ferropénica, en la anemia megaloblástica y en la mielofibrosis, pero es típica de la eliptocitosis hereditaria. Tienen esta forma los eritrocitos del camello, de la salamandra y de la gallina.
Equinocitosis
También llamados estereocitos o astrocitos, consiste en la existencia de unos hematíes con espículas cortas y distribuidas regularmente a lo largo de toda su superficie. Se produce, por ejemplo, en la uremia, cuando los hematíes son pobres en K+ y en las hepatopatías neonatales.
Esferocitosis
Consiste en la existencia de unos hematíes con una forma esférica, que habitualmente también son de pequeño tamaño (microesferocitos). Se produce en la hidrocitosis, en la anemia inmunohemolítica y, sobre todo, en la esferocitosis hereditaria.
Esquistocitosis
Consiste en la existencia de unos hematíes fragmentados (esquistocitos). Se produce en la anemia microangiopática, en la hemólisis mecánica por la presencia de una prótesis valvular en el corazón y en las quemaduras graves.
Estomatocitosis
Consiste en la existencia de unos hematíes con una invaginación central en forma de boca. Estos eritrocitos son realmente discos unicóncavos. Se produce en el alcoholismo y en las hepatopatías crónicas.
Excentrocitosis
Consiste en la existencia de unos hematíes cuya Hb está concentrada en uno de sus polos. Se produce en el déficit de glucosa-6-fosfato deshidrogenasa (G6FD).
Keratocitosis
Consiste en la existencia de unos hematíes con dos espículas en su superficie. Se produce en la anemia hemolítica microangiopática, en la hemólisis por prótesis cardiacasy en el hemangioma cavernoso.
Poiquilocitosis
Consiste en la existencia de unos hematíes con una sola prolongación alargada que les confiere el aspecto de una raqueta o de lágrima (dacriocitos). Se produce, por ejemplo, en la talasemia.
ALTERACION DE COLORES:
Los hematíes normocrómicos presentan, con los métodos de tinción habituales, una coloración rosada (eosinófila). Además, ésta coloración es más intensa en la periferia que en el centro.
Anisocromía
Consiste en una falta de uniformidad en la coloración entre unos hematíes y otros. La coexistencia de dos poblaciones de hematíes, con coloraciones distintas, se produce por ejemplo en:
- El inicio del tratamiento de la anemia carencial.
- Los enfermos con anemia hipócroma que son transfundidos.
Hipocromía
Consiste en la existencia de unos hematíes pálidos y con aumento de la claridad central (hematíes hipocrómicos y anulocitos). Se produce, por ejemplo, en la anemia ferropénica.
Hipercromía
Consiste en la existencia de unos hematíes intensamente coloreados (hematíes hipercrómicos). La única hipercromía real es la que se produce en la esferocitosis hereditaria.
Policromasia
Consiste en la existencia de unos hematíes que presentan una coloración ligeramente basófila. Realmente, estas células son reticulocitos.
INCLUSIONES INTRAERITROCITARIAS :
Normalmente, los hematíes sólo contienen Hb, por lo que en su interior es homogéneo. Sin embargo, en algunas ocasiones se pueden encontrar elementos extraños en su interior
Normalmente, los hematíes sólo contienen Hb, por lo que en su interior es homogéneo. Sin embargo, en algunas ocasiones se pueden encontrar elementos extraños en su interior
Sustancia granulofilamentosa
La sustancia granulofilamentosa o reticulofilamentosa procede, fundamentalmente, de restos ribosómicos agregados. Consiste en una trama granulosa visible mediante la coloración con azul de cresil brillante. Es propia de los reticulocitos.
Cuerpo de Howell-Jolly
Es un pequeño residuo nuclear. Consiste en un grumo visible en el interior de los hematíes y que se tiñe, de un color que oscila entre el rojo oscuro y el negro, con los colorantes habituales. Aparece en sujetos esplenectomizados y en los que padecen sprue.
Cuerpos de Heinz
Son precipitados de Hb. Consisten en una serie de pequeñas granulaciones que se sitúan en la periferia de los hematíes y que se tiñen de color púrpura con una solución de cristal violeta. Se producen en enfermedades congénitas que comportan una inestabilidad de la Hb, que hace que esta se desnaturalice y precipite en presencia de algunos medicamentos.
Cuerpo de Papenheimer
También se llaman gránulos sideróticos. Son acúmulos de hemosiderina unida a proteínas. Consisten en gránulos basófilos, con las tinciones habituales, que además, se tiñen también de azul con el colorante de Perls (azul de Prusia). Se producen en los enfermos esplenectomizados y en las anemias sideroacrésticas.
Punteado basófilo
Pueden ser agregados ribosómicos originados por una degeneración vacuolar del citoplasma o precipitados de cadenas globínicas libres. Consiste en puntitos basófilos, con las tinciones habituales, de tamaño variable y dispersos por toda la superficie del hematíe. Se tiñen con tinción de Perls. Se produce en las intoxicaciones por plomo, y también en la talasemia y en la leucemia.
Anillos de Cabot
Están formados por restos de la membrana nuclear o de microtúbulos. Consisten en una especie de hilos basófilos, con las tinciones habituales, que adoptan una forma de anillo o de ocho y que pueden ocupar toda la periferia celular. Se produce en la anemia megaloblástica.
INCLUSIONES PARASITARIAS
SON EJEMPLOS, LAS QUE SE ENCUENTRAN EN LOS HEMATÍES PARASITAZOS POR DISTINTAS FORMAS EVOLUTIVAS DEL PLASMODIUM. ASÍ PUES, SI EL HEMATÍE ESTA PARASITAZO POR UN TROFOZOITO INICIAL, LA IMAGEN PERCIBIDA DENTRO DEL HEMATÍE TIENE FORMA ANULAR (ANILLO PALÚDICO). EN LA BABESIOSIS TAMBIÉN SE PUEDEN OBSERVAR IMÁGENES, CON ASPECTO DE ANILLO, EN EL INTERIOR DE LOS HEMATÍES. SIN EMBARGO, EN ALGUNAS ESPECIES DE BABESIA, LOS TROFOZOITOS GENERAN IMÁGENES EN FORMA DE PERA EN EL INTERIOR DE LOS ERITROCITOS.
SON EJEMPLOS, LAS QUE SE ENCUENTRAN EN LOS HEMATÍES PARASITAZOS POR DISTINTAS FORMAS EVOLUTIVAS DEL PLASMODIUM. ASÍ PUES, SI EL HEMATÍE ESTA PARASITAZO POR UN TROFOZOITO INICIAL, LA IMAGEN PERCIBIDA DENTRO DEL HEMATÍE TIENE FORMA ANULAR (ANILLO PALÚDICO). EN LA BABESIOSIS TAMBIÉN SE PUEDEN OBSERVAR IMÁGENES, CON ASPECTO DE ANILLO, EN EL INTERIOR DE LOS HEMATÍES. SIN EMBARGO, EN ALGUNAS ESPECIES DE BABESIA, LOS TROFOZOITOS GENERAN IMÁGENES EN FORMA DE PERA EN EL INTERIOR DE LOS ERITROCITOS.

No hay comentarios:
Publicar un comentario